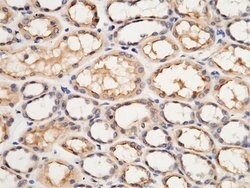
Invitrogen USH1C Polyclonal Antibody 100 &mu;L; Unconjugated:Antibodies,

missing translation for 'onlineSavingsMsg'
Learn More
Learn More
Invitrogen™ USH1C Polyclonal Antibody
Rabbit Polyclonal Antibody
Brand: Invitrogen™ PA581109
This item is not returnable.
View return policy
Description
This product is preservative free. It is recommended to add sodium azide to avoid contamination (final concentration 0.05%-0.1%). This antibody has specificity for Human USH1C/Harmonin.
This gene encodes a scaffold protein that functions in the assembly of Usher protein complexes. The protein contains PDZ domains, a coiled-coil region with a bipartite nuclear localization signal and a PEST degradation sequence. Defects in this gene are the cause of Usher syndrome type 1C and non-syndromic sensorineural deafness autosomal recessive type 18. Multiple transcript variants encoding different isoforms have been found for this gene.
Specifications
| USH1C | |
| Polyclonal | |
| Unconjugated | |
| USH1C | |
| 2010016F01Rik; AIE75; AIE-75; Antigen NY-CO-38/NY-CO-37; autoimmune enteropathy-related antigen AIE-75; DFNB18; DFNB18A; harmonin; harmonin a1; harmonin pseudogene; hypothetical protein LOC530709; hypothetical protein LOC564412; NY-CO-37; NY-CO-38; PDZ domain-containing protein; PDZ-45; PDZ73; PDZ-73; PDZ-73 protein; PDZ-73/NY-CO-38; PDZD7C; Protein PDZ-73; Renal carcinoma antigen NY-REN-3; USH1 protein network component harmonin; Ush1c; ush1cpst; Usher syndrome 1C; Usher syndrome 1C (autosomal recessive, severe); Usher syndrome 1C homolog; usher syndrome type-1C protein; Usher syndrome type-1C protein homolog; zgc:136806 | |
| Rabbit | |
| Antigen Affinity Chromatography, Protein A | |
| RUO | |
| 10083 | |
| Store at 4°C short term. For long term storage, store at -20°C, avoiding freeze/thaw cycles. | |
| Liquid |
| ELISA, Immunohistochemistry (Paraffin), Immunoprecipitation, Western Blot | |
| 1 mg/mL | |
| PBS with no preservative | |
| Q9Y6N9 | |
| USH1C | |
| Recombinant Human USH1C/Harmonin protein (Met1-Phe552). | |
| 100 μL | |
| Primary | |
| Human | |
| Antibody | |
| IgG |
Product Content Correction
Your input is important to us. Please complete this form to provide feedback related to the content on this product.
Product Title
Spot an opportunity for improvement?Share a Content Correction